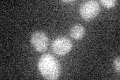
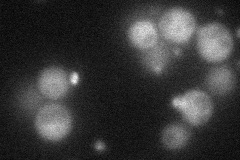
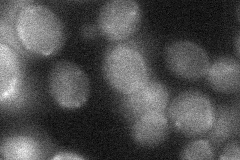
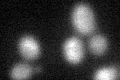

View description
SET domain protein of unknown function; deletion heterozygote is sensitive to compounds that target ergosterol biosynthesis, may be involved in compound availability
Localization:
Intensity:
Fold change:
Significance:
-
C’ GFP library in SD
below threshold14.23 -
N' NOP1pr-GFP in SD
cytosol,punctate48.5907 -
N' TEF2pr-mCherry in SD

cytosol12.8142 -
N' NATIVEpr-GFP in SD

below threshold19.5977 -
N' TEF2pr-VC and Cyto-VN in SD
below threshold24.7537 -
C’ GFP library in SD+DTT
cytosol18.391.29No -
C’ GFP library in SD+H2O2

cytosol17.871.25No -
C’ GFP library in Starvation Media

cytosol23.11.62No -
C’ GFP library on the background of Pup2-DaMP

below threshold -
C’ GFP library on the background of CCT mutant

below threshold16.57671.16458No
